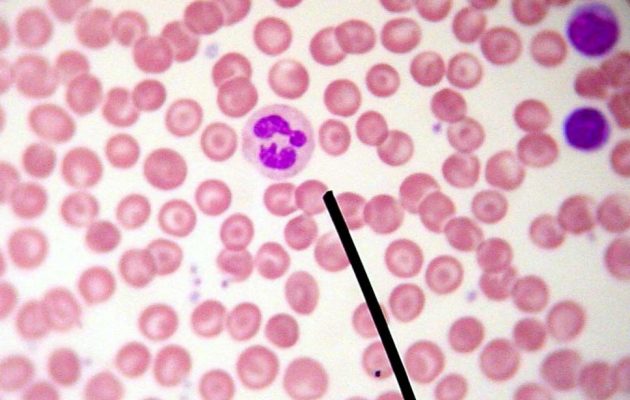

Лейкоциты, или белые кровяные тельца, играют важную роль в иммунной системе, защищая организм от инфекций и воспалений. Повышенный уровень лейкоцитов в крови, называемый лейкоцитозом, может указывать на различные заболевания и состояния, требующие внимания. В статье рассмотрим, что означает повышенное содержание лейкоцитов, причины этого явления и шаги для диагностики и лечения. Эта информация будет полезна пациентам и специалистам для понимания изменений в анализах крови.
Что это за болезнь
Лейкоцитоз – это серьезное заболевание, к которому следует относиться с вниманием. Его показатели могут указывать на различные патологии. Существует два основных типа этого недуга:
Доброкачественный лейкоцитоз обычно является признаком болезни, не связанной непосредственно с кровью и процессами кроветворения. Об этом мы поговорим подробнее ниже.
Злокачественный лейкоцитоз чаще всего указывает на наличие онкологических заболеваний крови. Он может быть связан с диагнозом лейкоз, при котором количество лейкоцитов в крови достигает таких уровней, что они начинают повреждать здоровые органы и ткани, вызывая метастазы. Повышенное количество лейкоцитов также может наблюдаться при других раковых заболеваниях костного мозга. Онкологические заболевания, затрагивающие кровь и костный мозг, являются одними из самых опасных и сложных в лечении. Поэтому, если общий анализ крови показывает повышенные лейкоциты, важно сразу исключить возможность наличия этой болезни.
Повышенный уровень лейкоцитов в крови может свидетельствовать о различных состояниях организма. Врачи отмечают, что лейкоциты, или белые кровяные клетки, играют ключевую роль в иммунной системе, защищая организм от инфекций и воспалений. Когда их количество превышает норму, это может указывать на наличие инфекции, воспалительного процесса или даже аллергической реакции. В некоторых случаях повышенные лейкоциты могут быть связаны с более серьезными заболеваниями, такими как лейкемия. Важно учитывать и другие показатели анализа, а также клинические симптомы пациента. Врачи рекомендуют не игнорировать результаты анализа и при необходимости проводить дополнительные исследования для установления точной причины изменения уровня лейкоцитов.

Возможные симптомы
Лейкоцитоз — это довольно коварное заболевание, которое редко проявляется явно. Обычно его симптомы скрываются под проявлениями других болезней. Однако есть одна особенность: именно эти сопутствующие недуги могут стать причиной лейкоцитоза. Обратите внимание на следующие признаки:
- Постоянная усталость и слабость, нехватка энергии;
- Головокружения и обморочные состояния;
- Необъяснимые кровотечения и появление синяков;
- Уменьшение аппетита, что может привести к потере веса;
- Резкое ухудшение зрения;
- Затрудненное дыхание;
- Чрезмерное потоотделение;
- Необъяснимое повышение температуры тела;
- Неясные боли в конечностях;
- Увеличение лимфатических узлов, печени и селезенки.
| Показатель | Значение | Возможное значение |
|---|---|---|
| Общее количество лейкоцитов | Выше нормы | Лейкоцитоз |
| Нейтрофилы | Повышены | Бактериальная инфекция, воспаление, стресс |
| Лимфоциты | Повышены | Вирусная инфекция, хроническое воспаление, некоторые виды лейкоза |
| Моноциты | Повышены | Хронические инфекции, аутоиммунные заболевания, туберкулез |
| Эозинофилы | Повышены | Аллергические реакции, паразитарные инфекции, астма |
| Базофилы | Повышены | Аллергические реакции, хронические воспалительные заболевания, миелопролиферативные заболевания |
| СОЭ (скорость оседания эритроцитов) | Повышена | Воспалительный процесс, инфекция, аутоиммунные заболевания |
| С-реактивный белок | Повышен | Острое воспаление, инфекция, повреждение тканей |
| Прокальцитонин | Повышен | Бактериальная инфекция, сепсис |
Причины лейкоцитоза
Лейкоцитоз может указывать на различные заболевания, поскольку кровь является одним из первых компонентов организма, реагирующих на изменения. Как уже упоминалось, это лишь симптом, а не самостоятельное заболевание. Повышение уровня лейкоцитов может быть вызвано следующими факторами:
- Инфекция – наиболее распространенная причина доброкачественного лейкоцитоза;
- Воспалительные процессы в органах;
- Травмы;
- Обострение сезонной аллергии;
- Неправильное питание, не обеспечивающее организм необходимыми веществами и витаминами;
- Стрессы и неврозы;
- Чрезмерные физические нагрузки.
Кроме того, увеличение количества лейкоцитов может быть побочным эффектом некоторых медикаментов. Обычно их уровень быстро восстанавливается после завершения курса лечения такими препаратами.
Чем грозит лейкоцитоз
Необходимо осознавать, что лейкоцитоз является лишь симптомом, а не самостоятельным заболеванием. Игнорирование этого состояния может привести к ухудшению или развитию более серьезных заболеваний, которые вызвали увеличение количества лейкоцитов в крови.
Следует также упомянуть, что лейкоцитоз может быть физиологическим. Это означает, что повышение уровня лейкоцитов не связано с каким-либо заболеванием. Однако даже в таких случаях важно снижать их количество. В противном случае это может привести к возникновению аутоиммунных заболеваний и аллергических реакций. Неправильная диагностика и отсутствие лечения лейкоцитоза могут стать причиной хронической усталости, апатии и снижения физической активности.
Если говорить о злокачественном лейкоцитозе, то запущенное лечение может иметь фатальные последствия. Этот тип лейкоцитоза часто указывает на наличие серьезных заболеваний. Онкологические заболевания, как правило, хорошо поддаются лечению на ранних стадиях. Симптомы лейкоцитоза, включая злокачественный, были описаны ранее. Если вы заметили у себя подобные признаки, не откладывайте визит к врачу. Это позволит провести лечение быстро и эффективно, минимизируя возможные неудобства.
Методы лечения
Лейкоцитоз требует внимания и лечения, однако не всегда это связано с госпитализацией или медикаментозной терапией. В некоторых ситуациях для восстановления нормального уровня лейкоцитов в крови достаточно внести изменения в образ жизни: наладить сбалансированное питание, заниматься умеренной физической активностью и снизить уровень стресса. Эти простые шаги положительно скажутся не только на показателях крови, но и на общем самочувствии.
Если же лейкоцитоз обусловлен каким-либо заболеванием, необходимо проводить целенаправленное лечение. Врач может назначить различные группы препаратов:
- Противовоспалительные средства;
- Антибактериальные препараты;
- Средства, снижающие уровень кислоты в моче.
Видео: виды лейкоцитов и их функции
В этом видео доктор Комаровский объяснит, что означает увеличение уровня лейкоцитов в крови.
Увеличение количества белых кровяных клеток, известных как лейкоциты, называется лейкоцитозом. Лейкоциты играют ключевую роль в иммунной системе человека, так как они защищают организм от различных угроз и предотвращают размножение вредоносных клеток.
Почему же иногда анализы показывают повышенное количество лейкоцитов в крови? Что это может означать и какие причины могут быть у этого состояния? Давайте разберемся.

Для чего нужны лейкоциты?
Основные функции белых кровяных клеток можно описать следующим образом:
- Они проникают в желудочно-кишечный тракт, захватывают питательные вещества и транспортируют их в кровь. Это особенно важно для новорожденных, которые, находясь на грудном вскармливании, получают вместе с материнским молоком готовые иммуноглобулины, способные защитить их от множества инфекций.
- Лейкоциты участвуют в формировании как клеточного, так и гуморального иммунитета, что является ключевым аспектом их защитной роли.
- Они уничтожают ненужные структуры, которые могут возникнуть еще в эмбриональном периоде, выполняя морфогенетическую функцию.
- Лейкоциты растворяют поврежденные ткани и выполняют гистолитическую задачу.
Подробный анализ крови включает в себя не только подсчет общего количества лейкоцитов, но и определение процентного соотношения различных типов белых кровяных клеток в мазке.
Норма лейкоцитов в крови
Анализ крови на содержание лейкоцитов является важным инструментом для выявления различных состояний организма. У взрослых нормальные показатели лейкоцитов варьируются от 4 до 8,8 х 10^9 /л.
У детей уровень лейкоцитов в крови обычно значительно выше. Для новорожденных нормальные значения составляют от 9,2 до 13,8 х 10^9 /л. У детей в возрасте от одного до трех лет нормой считается диапазон от 6 до 17 х 10^9 /л. Для детей до десяти лет нормальные показатели лейкоцитов колеблются от 6,1 до 11,4 х 10^9 /л.
Во время беременности уровень лейкоцитов в крови, как правило, повышается, и ближе к родам такие показатели считаются нормальными — чем больше нагрузка на организм, тем выше уровень лейкоцитов.
Когда повышение лейкоцитов можно считать нормой
В течение суток уровень лейкоцитов в крови может варьироваться. В некоторых ситуациях он может даже превышать нормальные показатели, но не стоит по этому поводу переживать.
Такой тип лейкоцитоза называется физиологическим, и его причины могут быть следующими:
- Курение.
- Стрессовые ситуации и сильные эмоциональные переживания.
- Питание. Некоторые продукты способны оказывать влияние на уровень лейкоцитов.
- Вторая половина беременности также может сопровождаться повышением лейкоцитов, что считается нормальным.
- Физическая активность и занятия спортом всегда вызывают изменения в уровне лейкоцитов.
- Пребывание в условиях высокой температуры воздуха. Это может быть как чрезмерное увлечение солнечными ваннами, так и работа в определенных производственных условиях. К этому пункту также относится посещение бань и саун.
Чтобы минимизировать влияние всех этих факторов, анализ крови рекомендуется сдавать в спокойном состоянии, утром и натощак. Если же результаты анализа показывают повышенные значения, это может указывать на патологический лейкоцитоз, связанный с наличием какого-либо заболевания.
Повышенные лейкоциты в крови: причины
Почему у взрослого человека наблюдается повышение уровня лейкоцитов в крови и что это может означать? Патологический лейкоцитоз сигнализирует о наличии проблем со здоровьем. Повышенные лейкоциты могут возникать по следующим причинам:
- Инфекционные заболевания: такие как бронхит, пневмония, ОРВИ и другие.
- Аутоиммунные болезни, при которых иммунная система начинает воспринимать собственные ткани как чуждые и реагирует на это.
- Хронические воспалительные процессы в любом органе также могут вызывать лейкоцитоз, хотя он может быть менее выраженным, так как организм адаптируется и борется менее активно.
- Острые бактериальные инфекции, например, холецистит, аппендицит, пиелонефрит. В таких случаях повышение уровня лейкоцитов обычно связано с увеличением нейтрофилов.
- Аллергические реакции – это ненормальная реакция иммунной системы, которая сопровождается повышенным синтезом лейкоцитов и иммуноглобулинов.
- Вирусные инфекции, такие как краснуха, гепатит, инфекционный мононуклеоз и ВИЧ.
- Увеличение уровня лейкоцитов может наблюдаться при сильной боли и эмоциональных стрессах, поскольку белые кровяные клетки реагируют на физическую и психоэмоциональную нагрузку.
- Гнойные инфекции (перитонит, абсцессы) или сепсис могут привести к очень высокому уровню лейкоцитов (до 50х10^9/л).
- Онкологические заболевания в различных органах и тканях часто сопровождаются значительным увеличением количества лейкоцитов в крови.
- Обширные ожоги и обморожения, при которых кожа теряет свою защитную функцию.
- При различных паразитарных инфекциях в крови наблюдается рост эозинофилов (одного из видов лейкоцитов).
Степень повышения лейкоцитов может отражать тяжесть заболевания и варьироваться в зависимости от возраста. Основное правило лечения лейкоцитоза заключается в том, чтобы выявить причину увеличения количества лейкоцитов в крови и устранить ее.
Какие симптомы?
Это состояние часто сопровождается следующими симптомами:
- общее недомогание, чувство усталости;
- умеренное и выраженное повышение температуры;
- ухудшение зрения, проблемы со сном;
- потеря веса, а также боли в суставах и мышцах;
- повышенное потоотделение, головокружение, снижение аппетита.
Иногда лейкоцитоз можно обнаружить только при проведении очередного общего анализа крови. Существует ряд малоизученных состояний, при которых могут наблюдаться увеличение СОЭ, лейкоцитов и температуры. Обычно со временем все показатели возвращаются к норме. Эти отклонения от нормы, как правило, не имеют явных проявлений.
Как понизить уровень лейкоцитов в крови
Лечение лейкоцитоза определяется врачом после проведения дополнительных исследований. Основная цель терапии заключается в устранении причин, вызвавших увеличение уровня лейкоцитов. Специального лечения для снижения количества лейкоцитов в крови не предусмотрено.
Если повышение уровня лейкоцитов обусловлено физиологическими факторами (неправильное питание, беременность, физическое перенапряжение), то для его нормализации необходимо внести изменения в образ жизни:
- соблюдать сбалансированное питание;
- уделять больше времени отдыху;
- избегать переохлаждения или перегрева, особенно при ослабленном иммунитете.
При обнаружении лейкоцитоза крайне важно не заниматься самолечением. Это состояние может быть временным или указывать на серьезные заболевания, требующие медицинского вмешательства. Только квалифицированный специалист сможет определить причины повышения уровня лейкоцитов и предложить соответствующие меры.
Повышенное количество лейкоцитов в крови может вызывать беспокойство, так как часто свидетельствует о наличии проблем в организме. Однако стоит учитывать, что белые кровяные клетки могут увеличиваться в ответ на различные раздражители, что иногда связано с недостаточной подготовкой к анализу. Например, уровень лейкоцитов может возрасти после приема обезболивающего, горячей ванны или обильного приема пищи перед сдачей крови. Чтобы убедиться в правильности результатов, рекомендуется повторно сдать анализ, чтобы точно определить, находятся ли лейкоциты в пределах нормы.
Лейкоциты – что это такое
Лейкоциты представляют собой клетки крови, которые находятся в плазме и играют ключевую роль в защите организма. Их белый цвет стал причиной того, что в английской терминологии они обозначаются как WBC (White Blood Cells). Это обозначение используется в анализах крови, так как английский язык является международным стандартом в области медицины.
Среди белых клеток выделяют несколько типов: лимфоциты, нейтрофилы, эозинофилы, моноциты и базофилы. Все они являются важными компонентами иммунной системы, и их основная функция заключается в защите организма от различных угроз.
Белые клетки формируются в костном мозге из «стволовых» клеток, которые делятся на несколько категорий. Костный мозг представляет собой мягкую губчатую ткань, находящуюся внутри костей. Наибольшее количество костного мозга содержится в крупных плоских костях, таких как тазовые кости и грудина. Для того чтобы костный мозг мог производить клетки крови, ему необходимо получать достаточное количество питательных веществ из пищи.
Практически все виды белых клеток, а также эритроциты и тромбоциты, образуются из миелоидных стволовых клеток. Исключение составляют лимфоциты, которые формируются из лимфоидных стволовых клеток и после завершения своего созревания поступают в кровеносную систему из костного мозга.
Лимфоциты делятся на три основных типа. В-лимфоциты отвечают за выработку антител, которые атакуют инфекционные агенты, такие как бактерии и вирусы. Т-лимфоциты поддерживают В-лимфоциты в процессе выработки антител. Клетки-киллеры, известные как естественные убийцы, защищают организм от инфекций, уничтожая зараженные клетки.
Зачем знать данные белых клеток
Анализ крови позволяет оценить общее состояние организма. Особенно наглядно это демонстрирует уровень лейкоцитов. Когда количество лейкоцитов в крови оказывается ниже нормы или, наоборот, превышает ее, для точной диагностики важно выяснить, какие именно виды белых клеток изменяются. Поэтому для определения, какие лейкоциты повышены, а какие понижены, проводят подсчет каждой их разновидности, что позволяет составить лейкоцитарную формулу.
Что касается нормального уровня лейкоцитов, то для мужчин и женщин он составляет в среднем 4,5 х 10^9 клеток на литр. При этом стоит отметить, что нормы для женщин и мужчин идентичны. Однако, если речь идет о детях, то показатели будут другими. Например, у детей в возрасте от 2 до 6 лет уровень лейкоцитов варьируется от 5 до 15,5 х 10^9, после чего он постепенно снижается до значений, характерных для взрослых.
Повышенное содержание лейкоцитов в крови, известное как лейкоцитоз, является обычной реакцией организма на различные раздражители, с которыми сталкивается иммунная система в процессе воспаления. Ответ на вопрос о том, почему наблюдается увеличение лейкоцитов, чаще всего связан с воспалительными процессами. Наиболее распространенными реакциями иммунной системы при высоком уровне лейкоцитов являются нейтрофилия (гранулоцитоз) и лимфоцитоз.
Почему повышены нейтрофилы
Если в организме наблюдается значительное увеличение количества лейкоцитов, что приводит к росту нейтрофилов (нейтрофилия), это может быть обусловлено различными факторами, как острыми, так и хроническими. Нейтрофилы — это один из первых типов белых кровяных клеток, которые реагируют на инфекцию и направляются для борьбы с патогенами. К основным причинам их повышения относятся:
- Инфекционные заболевания.
- Воспалительные процессы.
- Некротические изменения.
- Воздействие физических факторов.
- Эмоциональный стресс.
- Применение медикаментов.
- Токсические вещества.
- Злокачественные новообразования.
- Гормональные сбои.
- Заболевания системы крови.
В ответ на воспалительные реакции нейтрофилы покидают свои запасы и поступают в общий кровоток, что и приводит к увеличению числа лейкоцитов в крови. В дальнейшем активируются резервы костного мозга, что объясняет, почему повышение уровня белых клеток часто сопровождается увеличением их производства.
Также стоит отметить, что количество лейкоцитов может увеличиваться за счет незрелых нейтрофилов, которые попадают в кровь раньше срока, поскольку более зрелые клетки погибли. Этот преждевременный выход незрелых нейтрофилов называется «левым сдвигом» и может указывать на наличие серьезных заболеваний, включая рак.
Кроме того, существует такое явление, как псевдонейтрофилия, которое возникает в результате иммунного ответа на острые стрессовые ситуации. Это могут быть интенсивные физические нагрузки, гормональные всплески или прием обезболивающих средств.
Аспления, то есть отсутствие функции селезенки, может привести к лейкоцитозу средней степени, когда наблюдается повышенное количество лейкоцитов из-за того, что нейтрофилам некуда храниться, так как селезенка является их основным резервуаром. Применение кортикостероидов также может способствовать увеличению уровня лейкоцитов и высвобождению нейтрофилов из костного мозга.
Почему возрастают лимфоциты
Уровень лимфоцитов обычно повышается при вирусных инфекциях, в то время как это происходит реже при бактериальных. Одним из примеров таких заболеваний является инфекционный мононуклеоз, который характеризуется увеличением В-лимфоцитов. При этом заболевании около 10% лимфоцитов принимают атипичную форму, а также наблюдается рост мелких лимфоцитов. На второй неделе болезни происходит увеличение активированных цитотоксических Т-лимфоцитов, которые уничтожают инфицированные В-лимфоциты.
Инфекционный мононуклеоз чаще всего встречается у подростков и молодых людей. Основные симптомы этого заболевания включают:
- Повышение температуры.
- Боль в горле.
- Лимфаденопатия (увеличение лимфатических узлов).
- Часто наблюдается увеличение селезенки.
Это заболевание чаще проявляется в детском возрасте и, как правило, имеет доброкачественный характер. Его причиной могут быть вирусы Коссака или В6, эховирус и аденовирус 12 (в последнем случае увеличение селезенки или лимфоаденопатия не наблюдаются).
Вирус HTLV-1 может вызвать преходящий лимфоцитоз, сопровождающийся высокой температурой, сыпью и легкой лимфаденопатией. В большинстве случаев заболевание проходит самостоятельно, однако иногда могут возникнуть осложнения, такие как лейкемия Т-лимфоцитов.
Другие причины лейкоцитоза
Увеличение уровня моноцитов может наблюдаться при различных заболеваниях, особенно в период восстановления после инфекций. Однако это также может быть связано с злокачественными новообразованиями, в частности миелопролиферативными расстройствами. Моноцитоз может возникать в результате вирусных и грибковых инфекций, а также глистных инвазий.
Повышенное количество моноцитов может привести к гемофагоцитическому синдрому, который характеризуется активным фагоцитозом эритроцитов, лейкоцитов и тромбоцитов. Этот синдром часто возникает на фоне вирусных и бактериальных инфекций, а также может быть связан с злокачественной лимфомой Т-лимфоцитов.
Увеличение уровня эозинофилов связано с различными иммунологическими нарушениями. При значительном накоплении эозинофилов могут образовываться кристаллоидные структуры, известные как кристаллоиды Шаро-Лейдена. Эозинофилию могут провоцировать:
- Аллергические заболевания.
- Астма.
- Экзема и атопические дерматозы.
- Паразитарные инфекции, такие как трихиноз, глисты и шистосомиаз.
- Разные инфекционные болезни, включая скарлатину, туберкулез и проказу.
- Синдром Леффлера.
- Легочная инфильтрация с эозинофилией.
- Лекарственные препараты, например, сульфонамиды и другие.
- Неоплазмы, включая опухоли и болезнь Ходжкина.
Увеличение уровня базофилов может наблюдаться при аллергических реакциях и также может указывать на хроническую миелоцитарную лейкемию. Повышение количества базофилов связано с полицитемией вера и экстрамедуллярным гематопоэзом. Базофилия также может возникать при гипотиреоидизме, когда щитовидная железа не вырабатывает достаточное количество гормонов.
Поражения костного мозга
Существуют более серьезные состояния, при которых наблюдается повышение уровня лейкоцитов, такие как лейкостаз, лейкемоидные и лейкоэритробластические реакции. Все эти состояния могут быть опасными для жизни, так как относятся к онкологическим заболеваниям.
Лейкостаз возникает в результате накопления значительного количества лейкоцитов в капиллярах и мелких сосудах мозга, легких и почек, что приводит к образованию лейкоцитарных тромбов. Это состояние может вызвать летальный исход из-за нарушения кровообращения и недостатка веществ, необходимых для нормального функционирования головного мозга. Повышение уровня лейкоцитов в крови при лейкостазе чаще всего наблюдается при миелоидной лейкемии, реже — при хронической лимфоцитической лейкемии. Увеличение количества лейкоцитов может быть связано с высоким содержанием миелоидных бластов.
Лейкемоидные реакции характеризуются присутствием незрелых лейкоцитов (бластов, промиелоцитов, миелоцитов и метамиелоцитов) в периферической крови. Эти реакции могут быть вторичными и возникать как при злокачественных, так и при доброкачественных опухолях. Уровень белых клеток в этом случае значительно повышен, и в анализах крови лейкоциты могут достигать значений от 50 до 100 х 10^9 клеток на литр, что существенно превышает норму.
Лейкоэритробластическая реакция схожа с лейкемоидной, но при этом наблюдается увеличение количества эритроцитов. Это состояние связано с нарушением работы костного мозга, что часто происходит при миелофиброзе (первичном или вторичном). Лейкоэритробластические реакции могут указывать на наличие экстрамедуллярного гематопоэза, который часто возникает при метастазах рака, когда опухоль распространяет раковые клетки в здоровые ткани. У новорожденных такие реакции могут сопровождаться тяжелой гемолитической анемией, известной как фетальный эритробластоз.
Еще одним заболеванием, при котором наблюдается повышенное количество лейкоцитов в крови и затрагивается костный мозг, является остеопетроз. Это редкое заболевание проявляется в детском возрасте и связано с нарушениями в остеокластах, которые теряют способность к резорбции костной ткани. В результате кости утрачивают возможность изменять форму и расти, а полости костного мозга, где должна производиться кровь, заменяются другими тканями. В итоге кроветворные элементы проникают в периферическое кровообращение.
Что такое лейкопения
Пониженное количество лейкоцитов в крови, известное как лейкопения, характеризуется снижением как общего числа лейкоцитов, так и отдельных их типов. Когда уровень лейкоцитов оказывается ниже нормы, организм теряет свою способность эффективно противостоять инфекциям.
Причины, способствующие снижению лейкоцитов, могут включать недостаточность костного мозга, заболевания, влияющие на периферическое кровообращение, или изменения в выработке нейтрофилов из резервов.
Наиболее часто наблюдается снижение уровня лейкоцитов, связанное с уменьшением числа нейтрофилов. Нейтропения, при которой количество лейкоцитов понижается, также называется гранулоцитопенией. Этот термин, хотя и является синонимом, охватывает также снижение эозинофилов, базофилов и нейтрофилов.
Среди причин, по которым костный мозг может снижать выработку нейтрофилов, можно выделить:
- Применение лекарственных препаратов.
- Апластическую анемию (гипоплазию костного мозга).
- Миелофиброз (раковые метастазы, грануломы, фиброз).
- Недостаточный гематопоэз (мегалобластическую анемию).
Существуют и другие формы лейкопении, когда количество лейкоцитов в крови оказывается низким. Например, эозинопения может возникать при синдроме Кушинга или при применении кортикостероидов. Если снижение связано с базофилами, это называется базопенией, и ее могут вызывать кортикостероиды, стресс, острое воспаление или гипертиреоз. Снижение моноцитов обозначается как моноцитопения, и в этом случае причиной может быть прием Преднизона.
Пониженное количество лейкоцитов также может наблюдаться при снижении только лимфоцитов. Одной из самых серьезных причин этого состояния является ВИЧ-инфекция. Это означает, что организм оказывается в уязвимом положении и не способен эффективно бороться с инфекциями и вирусами. Для выявления причины и назначения лечения необходимо повторно сдать анализ крови. Если результаты останутся неудовлетворительными, потребуется пройти дополнительные обследования.
https://youtube.com/watch?v=1zFMpZ8SwSc
Диагностика лейкоцитоза
Лейкоцитоз — это состояние, при котором уровень лейкоцитов в крови превышает нормальные значения. Нормальный диапазон для взрослых составляет от 4 000 до 10 000 лейкоцитов на микролитр крови. Повышение этого показателя может быть вызвано различными факторами, и его диагностика требует комплексного подхода.
Первым шагом в диагностике лейкоцитоза является определение его степени и типа. Лейкоциты делятся на несколько подгрупп, включая нейтрофилы, лимфоциты, моноциты, эозинофилы и базофилы. Каждая из этих подгрупп может реагировать на различные патологии, и их относительное количество может дать важную информацию о причине повышения общего числа лейкоцитов.
Для диагностики лейкоцитоза врач может назначить общий анализ крови, который включает подсчет лейкоцитов и их дифференциацию. Важно учитывать, что лейкоцитоз может быть реакцией на инфекцию, воспаление, стресс, аллергические реакции или даже на физическую нагрузку. Например, при бактериальных инфекциях чаще всего наблюдается увеличение нейтрофилов, тогда как вирусные инфекции могут приводить к повышению лимфоцитов.
Кроме того, необходимо учитывать и другие лабораторные показатели, такие как уровень гемоглобина, тромбоцитов и соотношение различных типов лейкоцитов. Это поможет исключить или подтвердить наличие сопутствующих заболеваний, таких как анемия или тромбоцитопения, которые могут влиять на общее состояние пациента.
Также важно учитывать клиническую картину и анамнез пациента. Врач должен собрать информацию о симптомах, которые могут указывать на инфекцию или воспаление, таких как лихорадка, озноб, боль или другие проявления. В некоторых случаях может потребоваться дополнительное обследование, включая рентгенографию, УЗИ или компьютерную томографию, чтобы выявить источник воспалительного процесса.
Лейкоцитоз может быть временным состоянием, вызванным, например, стрессом или физической нагрузкой, или же хроническим, что может указывать на более серьезные заболевания, такие как лейкемия или другие онкологические процессы. Поэтому важно не только выявить факт повышения уровня лейкоцитов, но и установить его причину, чтобы назначить адекватное лечение.
Роль питания в уровне лейкоцитов
Питание играет ключевую роль в поддержании нормального уровня лейкоцитов в крови. Лейкоциты, или белые кровяные клетки, являются важной частью иммунной системы, и их количество может варьироваться в зависимости от множества факторов, включая диету. Неправильное или несбалансированное питание может привести к повышению уровня лейкоцитов, что может быть признаком воспалительных процессов или других заболеваний.
Одним из основных факторов, влияющих на уровень лейкоцитов, является потребление белка. Белки, содержащиеся в мясе, рыбе, молочных продуктах и бобовых, необходимы для синтеза антител и других компонентов иммунной системы. Недостаток белка может привести к снижению функции лейкоцитов, что, в свою очередь, может вызвать их компенсаторное увеличение в ответ на воспаление или инфекцию.
Также важно учитывать влияние витаминов и минералов на уровень лейкоцитов. Например, витамин C, содержащийся в цитрусовых, ягодах и овощах, способствует укреплению иммунной системы и может помочь в регулировании уровня лейкоцитов. Витамины группы B, особенно B6 и B12, играют важную роль в образовании крови и поддержании нормального уровня лейкоцитов. Недостаток этих витаминов может привести к анемии и изменению количества белых кровяных клеток.
Кроме того, минералы, такие как цинк и медь, также необходимы для нормального функционирования иммунной системы. Цинк, содержащийся в орехах, семенах и морепродуктах, участвует в процессе деления клеток и синтеза ДНК, что важно для образования лейкоцитов. Недостаток цинка может привести к снижению уровня лейкоцитов и ослаблению иммунного ответа.
Не менее важным аспектом является баланс между потреблением углеводов и жиров. Избыточное потребление простых углеводов и насыщенных жиров может привести к воспалительным процессам в организме, что, в свою очередь, может вызвать повышение уровня лейкоцитов. Поэтому рекомендуется придерживаться сбалансированной диеты, богатой сложными углеводами, полезными жирами и клетчаткой, чтобы поддерживать нормальный уровень лейкоцитов и общее здоровье.
Наконец, стоит отметить, что гидратация также играет важную роль в поддержании нормального уровня лейкоцитов. Недостаток жидкости может привести к сгущению крови и изменению концентрации клеток, включая лейкоциты. Поэтому важно следить за достаточным потреблением воды и других жидкостей в течение дня.
В заключение, правильное питание является важным фактором, влияющим на уровень лейкоцитов в крови. Сбалансированная диета, богатая белками, витаминами и минералами, а также достаточное потребление жидкости помогут поддерживать нормальный уровень лейкоцитов и укрепить иммунную систему.
Профилактика повышения лейкоцитов
Профилактика повышения уровня лейкоцитов в крови играет важную роль в поддержании общего здоровья и предотвращении различных заболеваний. Лейкоциты, или белые кровяные клетки, являются ключевыми компонентами иммунной системы, и их уровень может повышаться в ответ на инфекции, воспаления и другие патологические состояния. Однако существуют меры, которые могут помочь предотвратить ненужное увеличение их количества.
Во-первых, важно поддерживать здоровый образ жизни. Это включает в себя сбалансированное питание, богатое витаминами и минералами, регулярные физические нагрузки и достаточное количество сна. Питание должно содержать достаточное количество антиоксидантов, таких как витамины C и E, которые помогают укрепить иммунную систему и снизить воспалительные процессы в организме.
Во-вторых, необходимо избегать стрессов и переутомления. Хронический стресс может негативно сказаться на иммунной системе, способствуя повышению уровня лейкоцитов. Практики релаксации, такие как йога, медитация или простые дыхательные упражнения, могут помочь снизить уровень стресса и поддерживать здоровье.
Также следует обратить внимание на профилактику инфекционных заболеваний. Вакцинация против распространенных инфекций, таких как грипп и пневмококковая инфекция, может значительно снизить риск заболеваний, которые могут привести к повышению уровня лейкоцитов. Кроме того, соблюдение правил личной гигиены, таких как регулярное мытье рук, может помочь предотвратить инфекции.
Не менее важным аспектом является регулярное медицинское обследование. Профилактические осмотры и анализы крови помогут выявить возможные проблемы на ранних стадиях и принять меры для их устранения. Если у вас есть предрасположенность к заболеваниям, связанным с повышением уровня лейкоцитов, важно находиться под наблюдением врача и следовать его рекомендациям.
Наконец, следует избегать вредных привычек, таких как курение и чрезмерное употребление алкоголя. Эти факторы могут негативно влиять на иммунную систему и способствовать развитию различных заболеваний, что, в свою очередь, может привести к повышению уровня лейкоцитов.
В заключение, профилактика повышения уровня лейкоцитов включает в себя комплексный подход, который сочетает в себе здоровый образ жизни, профилактику инфекций, регулярные медицинские обследования и отказ от вредных привычек. Соблюдение этих рекомендаций поможет поддерживать нормальный уровень лейкоцитов и общее здоровье организма.